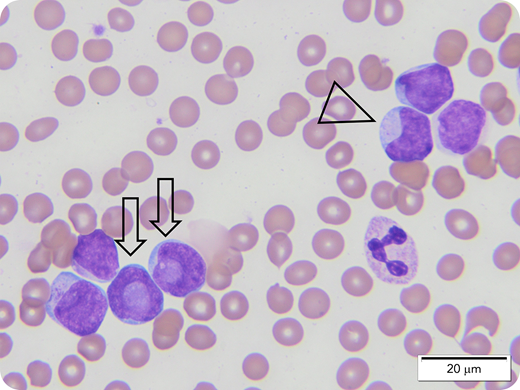
A 4-year-old child presented with fever and was found to have leukocytosis, anemia, and thrombocytopenia (white blood cells = 136 200/µL; hemoglobin = 8.7 g/dL; platelets = 108 000/µL). Examination of a peripheral blood smear showed blasts constituting 88% of cells. The blasts were mostly medium sized with scant to moderate light-blue cytoplasm; round, oval to irregular nuclei; smooth chromatin; and conspicuous nucleoli. Most blasts showed cytoplasmic red granules, but no Auer rods were seen. The preliminary impression was acute myeloid leukemia (AML). Immunophenotyping showed blasts expressing myeloperoxidase, CD33, CD56 (partial), CD117 (partial), CD11c with negative HLA: Dr., CD34, and CD15. This immunophenotype raised the possibility of acute promyelocytic leukemia (APL). Molecular study to exclude t(15;17) was initiated, and staining of additional peripheral blood smears using a manual method (for better morphologic details) was requested. Review of these slides demonstrated blasts with characteristic cup-shaped nuclei (×100 objective), typical of AML with a normal karyotype, positive FLT-3, and NPM1 mutation. Based on the classic morphologic findings, the patient was started on non-APL treatment. Cytogenetic findings became available later, confirming a normal karyotype, positive FLT-3 internal tandem duplication, and NPM1 mutation.

A 4-year-old child presented with fever and was found to have leukocytosis, anemia, and thrombocytopenia (white blood cells = 136 200/µL; hemoglobin = 8.7 g/dL; platelets = 108 000/µL). Examination of a peripheral blood smear showed blasts constituting 88% of cells. The blasts were mostly medium sized with scant to moderate light-blue cytoplasm; round, oval to irregular nuclei; smooth chromatin; and conspicuous nucleoli. Most blasts showed cytoplasmic red granules, but no Auer rods were seen. The preliminary impression was acute myeloid leukemia (AML). Immunophenotyping showed blasts expressing myeloperoxidase, CD33, CD56 (partial), CD117 (partial), CD11c with negative HLA: Dr., CD34, and CD15. This immunophenotype raised the possibility of acute promyelocytic leukemia (APL). Molecular study to exclude t(15;17) was initiated, and staining of additional peripheral blood smears using a manual method (for better morphologic details) was requested. Review of these slides demonstrated blasts with characteristic cup-shaped nuclei (×100 objective), typical of AML with a normal karyotype, positive FLT-3, and NPM1 mutation. Based on the classic morphologic findings, the patient was started on non-APL treatment. Cytogenetic findings became available later, confirming a normal karyotype, positive FLT-3 internal tandem duplication, and NPM1 mutation.
A 4-year-old child presented with fever and was found to have leukocytosis, anemia, and thrombocytopenia (white blood cells = 136 200/µL; hemoglobin = 8.7 g/dL; platelets = 108 000/µL). Examination of a peripheral blood smear showed blasts constituting 88% of cells. The blasts were mostly medium sized with scant to moderate light-blue cytoplasm; round, oval to irregular nuclei; smooth chromatin; and conspicuous nucleoli. Most blasts showed cytoplasmic red granules, but no Auer rods were seen. The preliminary impression was acute myeloid leukemia (AML). Immunophenotyping showed blasts expressing myeloperoxidase, CD33, CD56 (partial), CD117 (partial), CD11c with negative HLA: Dr., CD34, and CD15. This immunophenotype raised the possibility of acute promyelocytic leukemia (APL). Molecular study to exclude t(15;17) was initiated, and staining of additional peripheral blood smears using a manual method (for better morphologic details) was requested. Review of these slides demonstrated blasts with characteristic cup-shaped nuclei (×100 objective), typical of AML with a normal karyotype, positive FLT-3, and NPM1 mutation. Based on the classic morphologic findings, the patient was started on non-APL treatment. Cytogenetic findings became available later, confirming a normal karyotype, positive FLT-3 internal tandem duplication, and NPM1 mutation.
For additional images, visit the ASH Image Bank, a reference and teaching tool that is continually updated with new atlas and case study images. For more information, visit http://imagebank.hematology.org.